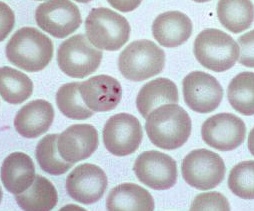
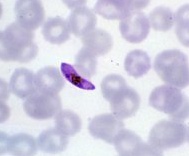
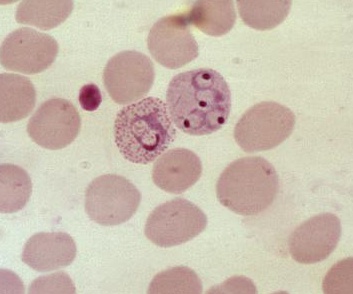

10 Parasites
Intestinal Parasites
Giardia
_..

backpack: Associated with campers
poop in water: Fecal oral transmission
cysts downstream: Transmitted by cysts
water bottle: Transmitted through poorly filtered drinking water
_..

metro train: Metronidazole treatment
_..

Distinct trophozoite form seen on stool O&P
ELISA boat: ELISA may be used for diagnosis


_..

yellow stool: Causes steatorrhea, or fatty stool (lactose intolerance due to border enzyme deficiency)
Entameoba Histolytica
_..

Do not enter, historical site: Entameoba histolytica
2 life cycles:
cyst in water: Cyst form
guy drinking: Cyst form infectious, ingested in contaminated waters
holding hands: Associated with men who have sex with men. Found to be related to anal oral transmission
Red cups in amoeba: trophozoites, invade colon and spread elsewhere
_..

liver map and tomb on right: Right lobe of liver is most common involved site of amoebic liver abscess
guy with stomach pain: Right upper quadrant pain
anchovy paste truck: Abscess described as having "anchovy past" consistency
stains on wall: Intestinal amebiasis: ulcerations in colon
red stool: Intestinal amebiasis: bloody diarrhea

_..

O&P: Diagnosis with stool O&P
red cups: Trophozoites with endocytosed red blood cells under microscope, pseudopods looking
flask: Intestinal biopsy may show flask-shaped lesions



_..

Metronidazole drug of choice treatment
pair of mice: Paramycin - luminal agent to eliminate cysts
queen iodus: Iodoquinol - luminal agent to eliminate cysts
Cryptosporidium
_..

cane: Severe diarrhea in HIV patients
Cryptosporidium outbreaks have been associated with drinking water supplies, swimming pools, and recreational water facilities.
_..

bubbles: Infectious cysts passed through stool
pipe: Sporozoites attach to intestinal wall, cause diarrhea and small intestine damage
_..
crystals: Cysts composed of 4 motile trophozoites
cape: Stains acid fast


_..

knit a sock: Nitazoxanide treatment
sock: Filtration can remove oocysts from water
spirit bird: Spiramycin treatment
Protozoa of the CNS
Toxoplasmosis
_..

cane: Immunocompromised at risk; immunocompetent asymptomatic
pregnant lady: Pregnant women at risk of transplacental transfer
bowl of meat: Cysts in undercooked meat
litter box and poop: T. gondii can be transmitted by cat feces
bird eggs in poops: Oocysts in feces
_..

extra lenses: Brain abscesses. Multiple ring enhancing lesions on CT or MRI
red: turban: Encephalitis
ping sticking out turban: Brain biopsy to differentiate from CNS lymphoma

_..

cat dressed as statue of liberty: ToRCHeS infection
milk on head: Congenital Toxoplasmosis: intracranial calcifications
bowl stuck on head, shaking: Congenital Toxoplasmosis: hydrocephalus and seizures
flash bulb looking like retina: Congenital Toxoplasmosis: Chorioretinitis
beethoven: Congenital Toxoplasmosis: Deafness


_..

dyed sulfa eggs: Sulfadiazine
pyramid on eggs: Pyrimethamine
$100 with cane: Prophylaxis for CD4 count <100
IgG key with positive kite: Prophylaxis for CD4 count <100 and seropositive for IgG
egg without pyramid: TMP-SMX for prophylaxis
Trypanosoma brucei
_..

multi colored tent: Variable surface glycoprotein coats, undergoing constant antigenic variation, thus recurrent fevers
single ribbon: Motile with flagella

_..

Sleeping beauty: African sleeping sickness
Tea fly: Tsetse fly vector, bite
map with pins: Gambiense, Rhodesiense
_..

sleeping: Coma
necklace: Cervical lymphadenopathy
cloth: Axillary lymphadenopathy
undulating hills: Recurrent fevers
_..

blood on finger and goat: Trypomastigotes seen on blood smear

_..

bar of mela soap: Melarsoprol treatment - CNS infection
bottle of serum: Suramin treatment for serum - Peripheral blood infection
Naegleria fowleri
_..
brain eating amoeba disease: primary amoebic meningoencephalitis
_..

Nigeria fall: Naegleria fowleri
scene: Associated with freshwater
wind surfing dude: Associated with patients involved in water-sports
water bottles: Associated with nasal irrigation systems and contact lens solution
_..

cribs: Enters CNS via cribiform plate
neck brace, red turban: primary amoebic Meningoencephalitis, inflammation of brain/meninges. Fever, neck stiffness, headache
head on rock: Rapidly fatal, poor prognosis
_..

needle in bottle: Lumbar puncture for diagnosis
frogs: Amphoterecin treatment


Protozoa of Blood
Trypanosoma cruzi
_..

Che Guevara. Che's Gas: Chagas disease, South and Central America, like Che
_..

"Kissing Bug" bites around victim's mouth, and deposits feces which can later be introduced by scratching area
bugs, red on heart: Transmitted by Reduviid, or "Kissing bug"

_..

asympatomatic acutely. Symptoms several years later
swollen colon: Megacolon with constipation
Tunneled up mole: Burrows into endocardium
floppy heart on bike: Dilated cardiomyopathy
snake with dilated snake: Mega-esophagus
_..

leaked red gas: Diagnosed by blood smear
red on heart: Trypanosomes may be seen within cardiac mycocytes on heart biopsy

cardiac biopsy:

_..

Furry, knee high moccasin boots: Nifurtimox treatment
Babesia
_..

Vampire babes: Babesiosis
Blood-related symptoms
_..

NE cross: NE United States
Robin of Ixodes: Ixodes tick
tick shield: tick-borne illness
deer antlers: Ixodes tick is a deer tick
sickle: Higher risk of severe disease in sickle cell disease
hole in robin's shirt: Higher risk of severe disease in asplenia
_..

cracked blood stained windows: Hemolytic anemia
yellow babe: Jaundice
Sweating robin: fever
torn robin shirt: Irregularly cycling fevers
_..

thick red floor: Babesioisis diagnosied by thick blood smear
maltese cross: Maltese cross appearance in red blood cells, tetrad of trophozoites, differentiates from malaria

_..

crows: ma-crow-lide: azithromycin treatment
Ato-vampire queen: atovaquone treatment
Plasmodium
_..

Malaria, especially in Africa
_..

mal area: Plasmodium malariae
buttons 1 and 4 colored like sun: Quartan fever cycle (72 hrs)
Only infects mature RBC
oval shield and axe: Plasmodium vivax and ovale
Only infects immature RBC
Hypnotist: P. vivax and P. ovale produce dormant hypnozoites, hides in liver
cow hide and liver spot: Hypnozoites in hepatocytes
Pendulum: Tertian fever cycle (48 hrs)
False mask: Plasmodium flaciparum
Infects all RBC
irregular torn shirt: irregular fever
red head dress: Cerebral malaria, parasitized RBC occlude capillaries in brain
banana head dress: RBC banana shaped on blood smear
gold belt: Parasitized RBC's occlude vessels to kidneys
gold chest plate: Parasitized RBC's occlude vessels to lungs, pulmonary edema
_..

sickle: Sickle cell, thalassemia, G6PD deficiency disease is protective against P. falciparum
_..

"Color queen" - chloroquine, beads join together as polymer, blocking plasmodium heme polymerase. High resistance
"Primal queen" - primaquine, can cause anemia in G6PD deficiency. Only treats hypnozoites
"Me-flock queen" - mefloquine, extra strong
backpack: Mefloquine prophylaxis for travelers to chloroquine resistant areas
"Ato-vampire queen" - atovaquone, strong
Iguana: Proguanil
backpack: Atovaquone/proguanil for travelers to chloroquine resistant areas
Chloroquine is effective in eradicating chloroquine-sensitive plasmodia from the bloodstream, but it has no activity against the latent hepatic infections established by P vivax and P ovale. Primaquine must be added to the regimen to completely eradicate the hypnozoites.
Primaquine has limited therapeutic activity against the erythrocytic forms of plasmodia, including trophozoites. Primaquine is not effective in treating chloroquine-resistant strains, which can be managed with mefloquine or quinine, among others.
No antimalarial agent specifically acts to prevent hemolysis. Primaquine is contraindicated in patients with glucose-6-phosphate dehydrogenase deficiency as the medication can cause hemolysis.
_..

artist: Use artemisins for severe P. falciparum infections
artist: Use IV artesunate for severe malaria infections; backup
"Dining queen" - quinidine; backup
Ivy: Artesunate and quinidine are delivered IV for severe malaria
_..

tin cans: Side effect of quinidine is cinchonism, including tinnitus/headaches
_..

mushroom: Anopheles mosquitoes carry sporozoites in saliva. Biting transmission to blood and then liver
liver spot: Sporozoites mature to trophozoites in liver. Divide and cause RBC to become less flexible = splenomegaly
RBC and small merozoites: Schizont divides into merozoites which burst from hepatocyte and infect RBCs
lifecycle continues in RBC: trophozoite -> schizont -> merozoites -> infect RBC
ring spot: Ring form of immature schizont
male/female symbol: Merozoite can also form gametocyte, ingested by female mosquitos and stored in saliva
Mosquito bite releases sporozoites into the bloodstream, which are eventually carried to the liver to infect hepatocytes. In hepatocytes, sporozoites divide into merozoites and are eventually released from hepatocytes to infect red blood cells (RBCs)
In RBCs, merozoites develop into trophozoites, which divide and eventually cause infected RBCs to become less flexible. These infected RBCs accumulate and are destroyed in the spleen, leading to splenomegaly.
In addition, trophozoites in infected RBCs can mature into schizonts, which rupture the RBC membrane, releasing merozoites that go on to infect other RBCs.
To complete the cycle, some merozoites turn into gametocytes, which are ingested by female mosquitoes. In the mosquito, gametocytes fuse forming a diploid zygote, which generates haploid sporozoites that are stored in mosquito salivary glands.
_..

Gems with blood smear: Blood stain and Giemsa stain to see parasites in RBCs
Schuffner dots: Schüffner dots are unique to P. vivax/ovale and are morphologic changes that occur in infected host erythrocytes. They are visible by light microscopy in blood smears, and appear as multiple brick-red dots.

ring shaped P. vivax

schizont

banana shaped P. falciparum
Leishmaniasis
_..

undeed brazilian man with brazillian flag: Leishmania Braziliensis - vertebrates are host
sand flies around zombie: Sandfly vector
_..

Leishmania braziliensis - cutaneous leishmaniasis, consumes flesh of victim and causes ulcers
goat inside cages: Amastigote is intracellular form, seen within macrophages
T bone steak: Stibugluconate treatment for cutaneous leishmaniasi

amastigote in macrophages:

_..

Donovin: Visceral leishmaniasis caused by Leishmania Donovani
black spots and sweating: Black fever, or kala-azar
empty pan: Bone marrow affected causing pancytopenia
sweating: Fevers
cow with spots: Hepatosplenomegaly
frogs: Amphoterecin B for visceral leishmaniasis
Intestinal nematodes
Enterobius vermicularis
_..

Vermin lady: Enterobius vermicularis, pin worm
crawling out of round hole with eggs at bottom: Female pin worms lay eggs at the anus
rats eating rocks: Fecal oral route. Scratch and put in mouth = auto infect
long cape with rocks: Scotch tape test shows eggs under the microscope
PAM: pyrantel pamoate
bending metal bars: albendazole
on tape:

Ancyclostoma duodenale and necator
_..

American dude, Ankle strings: Ancyclostoma duodenale
American dude: Neck strings: Necator americanus
hook: hookworm
red boots: Hookworm larvae penetrate skin of soles of feet (walking bare foot)
arrow on suit: blood stream —> lungs (coughed and swallowed) —> GI tract
iron dangling with microcytic and hypochromic holes: iron deficiency anemia
grenades fallen in water: eggs in stool
Eo sling shot boy with bilobe sling shot: eosinophilia
PAM: pyrantel pamoate
bending metal bars: albendazole. Secondary
cutaneous larva migrans:

A. Lumbricoides
_..

lumber man: Ascaris lumbricoides, large round worm
eating eggs in contaminated food/water
arrow on suit: blood stream —> lungs (coughed and swallowed) —> GI tract
bronchial tree on chest: respiratory symptoms
rocks obstructing: intestinal obstruction at ileocecal valve, malnutrition
Acorn in puddle: diagnosis by eggs in feces
Eosinophil granules: eosinophilia
bending metal bars: albendazole, microtubule inhibitor (avoir in pregnant women)


Strongyloides
_..

Strong guy: Strongyloides stercoralis
red boots: larvae penetrate skin of soles of feet
arrow on suit: blood stream —> lungs (coughed and swallowed) —> GI tract
round rocks in wall: Autoinfection: Strongyloides larvae hatch from eggs laid in intestinal wall, repenetrate wall, enter blood stream to lungs
larvae in water: diagnosis by larvae in stool, not eggs
Eosinophil granules: eosinophilia
bending metal bars: albendazole, microtubule inhibitor (avoir in pregnant women)
river mectin, no dumping, drain to river sign: ivermectin


Trichinella
_..

Spiral tricksters: Trichinella spiralis
pork: undercooked pork/bear
red pipes: Larvae enter blood stream
striated brick wall: Larvae travel to striated muscle
explosives on wall: Larvae form cysts within striated muscle
red glasses: Periorbital edema
green drool: Vomiting
sweat: Fever
fire: muscle inflammation, myalgia
Eosinophil granules: eosinophilia
bending metal bars: albendazole, microtubule inhibitor (avoir in pregnant women)

Tissue Nematodes
Dracunculus Medinensis
_..

Dracula: Dracunculus medinensis
water cooler and cupapods cup: D. medinensis transmitted by water contaminated with copepods containing larvae
Larvae in copepods
Untied shoe laces: Adult females emerge from painful ulcer in skin
eo sling shot boy: Eosinophilia
Shoe lace around water cooler: extract via match stick and twist slowly


Onchocerca Volvulus
_..

Onchocerca volvulus, river blindness
black fly bites human host, infiltrates skin, mature to adults, produce microfilariae
chemical stains: Hyper and hypo-pigmented spots occur with onchodermatitis
hand cover eyes: Microfilariae in eye cause blindness
pink granules: Eosinophilia
microscopes: Microfilariae seen in skin biopsy under microscope
rivermectin sign: Ivermectin
in vesicles:

Wuchereria bancrofti
_..

Witch craft: Wuchereria bancrofti
mosquitos flying around: W. Bancrofti transmitted by mosquitos
large pants: Elephantiasis: long standing lymphedema
ruffled collar and arm pit: Lymphadenopathy
coughing: Cough from microfilariae in lungs
thick smear of blood on hat: Organisms seen on thick blood smear
granules: Eosinophilia
Diet and carb magazine: Diethylcarbamazine


T. Canis
_..

wolfman: Toxocara canis
aka visceral larva migrans
stinky poop bag: T. canis transmitted by ingesting food contaminated with dog or cat feces
larva migrans: never mature, circulates body as larva
sleep mask: Ocular larva migrans leads to blindness
granules: Eosinophilia
bending metal chair legs: Albendazole

Loa Loa
_..

loa loa lagoon
flies: L. loa transmitted by deer flies
lumps over arms/legs: Local subcutaneous swellings. Loa loa causes transient subcutaneous areas of localized angioedema and erythema on the extremities and face known as Calabar swellings. Pain or itching may precede the development of these lesions.
worm in eye ball: Adult worms can migrate across conjunctiva
thick smear of blood on face: Organisms seen on thick blood smear
granules: Eosinophilia
Diet and carb magazine: Diethylcarbamazine
bending chair: Albendazole


Intermediate host for T. saginata is cattle
Intermediate host for T. solium is pigs
Taenia solium
Taenia saginata
Hooks on proglottid heads of T. solium seen on O&P
Neurocysticercosis - causes seizures. "Swiss cheese" appearance on head CT.
Ingest egg in stool: neurocysticercosis
Ingest larvae in meat: intestinal infection
Taenia eggs transmitted by water contaminated with animal feces
Praziquantel treatment
Albendazole treatment
Diphyllobothrium latum \xe2\x80\x93 fish tapeworm
B12 deficiency
Cobalamin deficiency
Megaloblastic anemia
Proglottid segments seen on stool O&P
D. latum is the longest tapeworm
Praziquantel
Niclosamide treatment
Echinococcus granulosus
Dogs are definitive host, sheep are intermediate host for E. granulosus
E. granulosus transmitted by dog feces
Eggshell calcifications in cyst on liver CT
Hydatid cyst in liver
Cysts rupture causes an anaphylactic reaction and acute abdomen
Eosinophilia
Swimmers at risk of infection
Snails are intermediate host
Migrate against portal flow
Schistosoma mansoni
Schistosoma japonicum
S. mansoni - large lateral spine
Paragonimus westermani
S. japonicum - small spine
Portal hypertension
Jaundice
S. haematobium - large terminal spine
Hematuria
S. haematobium - risk of bladder cancer
Praziquantel treatment
Snails are intermediate host
Snails are intermediate host
Clonorchis sinensis
Biliary fibrosis
Cholangiocarcinoma
Pigmented gallstones
Operculated eggs on O&P
Praziquantel treatment
Chronic cough with bloody sputum
Transmitted through consumption of raw or undercooked crab meat with larvae
Operculated eggs on O&P
Praziquantel treatment
Last updated